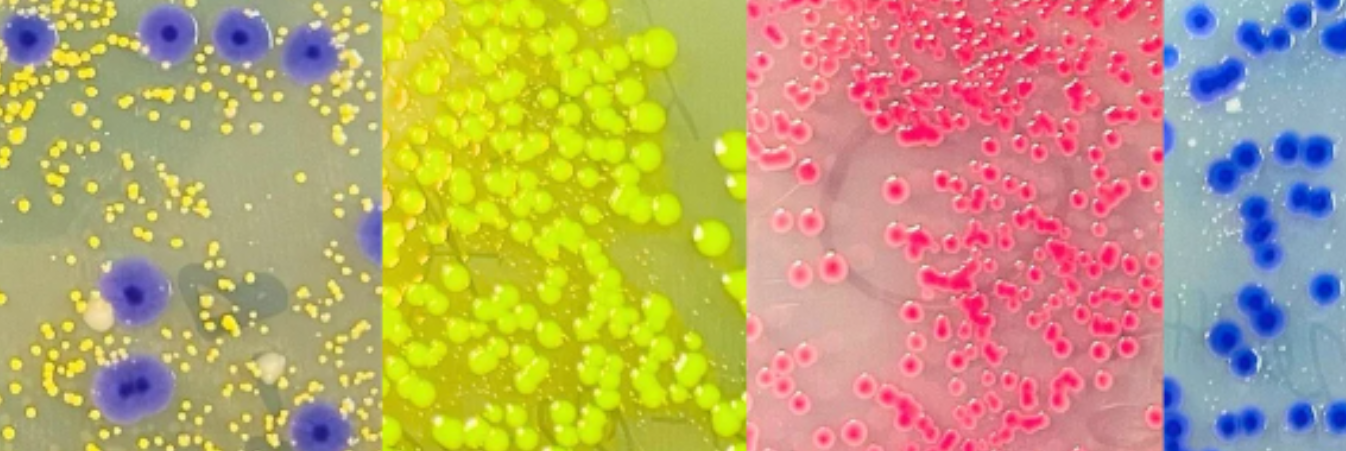
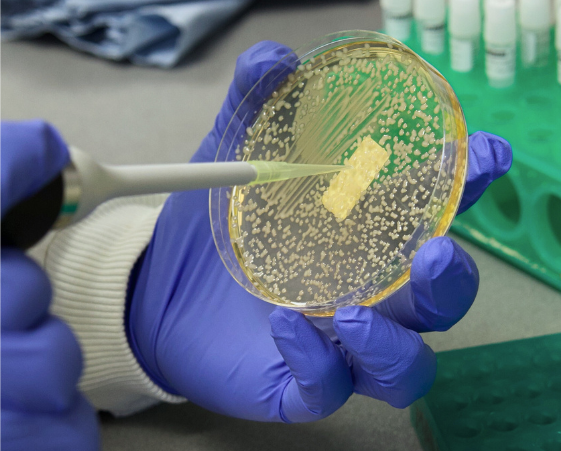

Synthetic Biology
We design and develop molecular tools to engineer genomes and use natural and synthetic biological parts to produce novel functions in plant cells.


We design and develop molecular tools to engineer genomes and use natural and synthetic biological parts to produce novel functions in plant cells.